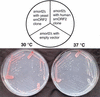

Systematic discovery of new genes in the Saccharomyces cerevisiae genome
- PMID: 12566404
- PMCID: PMC420365
- DOI: 10.1101/gr.232903
Systematic discovery of new genes in the Saccharomyces cerevisiae genome
Abstract
We used genome-wide comparative analysis of predicted protein sequences to identify many novel small genes, named smORFs for small open reading frames, within the budding yeast genome. Further analysis of 117 of these new genes showed that 84 are transcribed. We extended our analysis of one smORF conserved from yeast to human. This investigation provides an updated and comprehensive annotation of the yeast genome, validates additional concepts in the study of genomes in silico, and increases the expected numbers of coding sequences in a genome with the corresponding impact on future functional genomics and proteomics studies.
Figures

References
-
- Andrade M.A., Daruvar, A., Casari, G., Schneider, R., Termier, M., and Sander, C. 1997. Characterization of new proteins found by analysis of short open reading frames from the full yeast genome. Yeast 13: 1363-1374. - PubMed
-
- Blandin G., Durrens, P., Tekaia, F., Aigle, M., Bolotin-Fukuhara, M., Bon, E., Casaregola, S., de Montigny, J., Gaillardin, C., Lepingle, A., et al. 2000. Genomic exploration of the hemiascomycetous yeasts: 4. The genome of Saccharomyces cerevisiae revisited. FEBS Lett. 487: 31-36. - PubMed
-
- Cliften P.F., Hillier, L.W., Fulton, L., Graves, T., Miner, T., Gish, W.R., Waterston, R.H., and Johnston, M. 2001. Surveying Saccharomyces genomes to identify functional elements by comparative DNA sequence analysis. Genome Res. 11: 1175-1186. - PubMed
Publication types
MeSH terms
Substances
LinkOut - more resources
Full Text Sources
Other Literature Sources
Molecular Biology Databases
